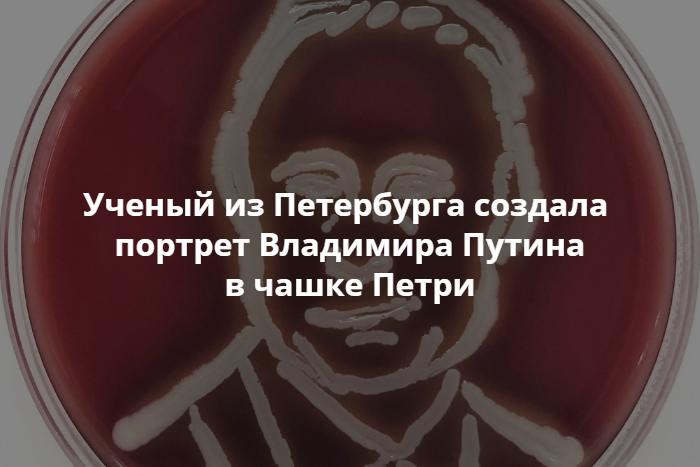

Original Material
Петербургский биолог создала портрет из микробов
Петербургский биолог Ольга Пинегина создала портрет Путина в чашке Петри с помощью стафилококка. Об этом сообщают организаторы конкурса «Красота микромира», в рамках которого биолог подготовила работу.
В этом году участники должны были подготовить рисунки на тему «Триптих из чашек Петри». Пинегина создала портрет президента РФ Владимира Путина, китайского лидера Си Цзиньпин, а также иероглиф, обозначающий счастье.

Конкурс «Красота микромира» проходит в России с 2016 года. Специалисты создают картины при помощи микробов в чашках Петри с питательной средой. В этом году итоги конкурса подведут 14 июня.
Петербургский ученый создал картину с «мостом глупости» из микробов
paperpaper.ru
На ней «газель» врезается в мост